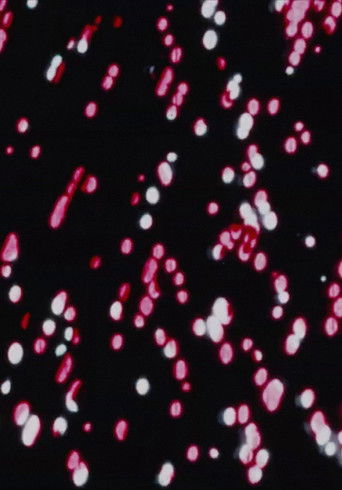
poster

Raindance
1972
16 min
⭐ 6.0/10
1 votes
Overview
RAINDANCE plays directly on the mind through programmatic stimulation of the central nervous system. Individual frames of the film are imprinted on the retina of the eye in a rhythm, sequence, and intensity that corresponds to Alpha-Wave frequencies of the brain. Preserved by the Academy Film Archive in 2010.
Production Countries
No production country data available.Spoken Languages
No spoken language data available.No streaming providers available for this content
Cast
Crew

Standish Lawder
Director
Robert Withers
Music
Posters